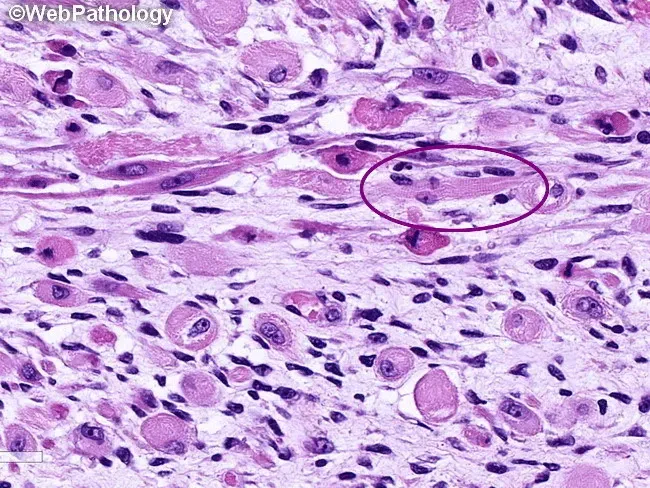
Embryonal Rhabdomyosarcoma Histopathology with Strap Cells

Overview - Malignant Muscle Mayhem
- Most common soft tissue sarcoma in children, arising from primitive mesenchymal cells (rhabdomyoblasts).
- Bimodal age distribution: peaks at 2-6 years and 15-19 years.
- Common Sites:
- Head & Neck (esp. orbit, parameningeal)
- Genitourinary (bladder, prostate, vagina)
- Extremities
⭐ Sarcoma botryoides, an embryonal subtype, presents as a submucosal "bunch of grapes" (botryoid) mass, classically in the vagina or bladder.

Histopathology - The Cellular Suspects
- Rhabdomyoblast: The diagnostic cell. Can be round, or elongated (tadpole/strap cells) with eosinophilic, granular cytoplasm.
- Cross-striations, resembling skeletal muscle, are pathognomonic but rarely seen.
- Major Subtypes:
- Embryonal (ERMS): Most common (~60%). Spindle cells in a myxoid stroma. Includes the Sarcoma Botryoides variant ("bunch of grapes").
- Alveolar (ARMS): Aggressive. Uniform, round cells lining fibrous septa, resembling lung alveoli.
- Immunohistochemistry (IHC) Markers: Myogenin (most specific), Desmin, and MyoD1.
⭐ Alveolar rhabdomyosarcoma is characterized by chromosomal translocations, typically t(2;13), creating a PAX3-FOXO1 fusion gene, which is linked to a poorer prognosis.
Clinical Features - Symptom Hotspots
- Site-dependent presentation. Mass effect is the primary driver of symptoms.
- Head & Neck (Most Common: ~40%)
- Orbit: Proptosis (most common orbital malignancy in childhood).
- Parameningeal (Nose, Sinuses, Middle Ear): Nasal/aural discharge, obstruction, cranial nerve palsies.
- Genitourinary (~25%)
- Bladder/Prostate: Hematuria, urinary obstruction, pelvic mass.
- Vagina/Uterus: 💡 Sarcoma botryoides - polypoid, grape-like mass protruding from the vagina.
- Paratesticular: Painless scrotal mass.
- Extremities (~20%): Rapidly enlarging, firm, painless mass.
⭐ Sarcoma botryoides is the embryonal subtype of rhabdomyosarcoma, classically presenting as a "bunch of grapes" mass in the vagina or bladder of young girls.
Diagnosis & Staging - The Workup Blueprint
-
Biopsy is Gold Standard: Incisional or excisional biopsy is mandatory for diagnosis.
- HPE: Small, round, blue cells; may show tadpole or strap cells.
- IHC Panel: Desmin, Myogenin, and MyoD1 are key markers.
-
Staging Workup: A systematic search for local and distant disease.
⭐ The most critical factor for staging is the post-surgical Clinical Group (IRS), which assesses residual disease after the initial surgery.
Management - The Treatment Takedown
- Multimodal approach is key: Surgery + Chemotherapy ± Radiotherapy.
- Goal of Surgery: Wide local excision with negative margins, if feasible.
- Chemotherapy: Backbone of treatment. Standard regimen is VAC (Vincristine, Actinomycin D, Cyclophosphamide) or IVA (Ifosfamide, Vincristine, Actinomycin D).
⭐ Treatment is stratified by the Intergroup Rhabdomyosarcoma Study (IRS) post-surgical clinical group, which assesses the extent of residual disease after surgery.
High‑Yield Points - ⚡ Biggest Takeaways
- Rhabdomyosarcoma is the most common soft tissue sarcoma in childhood, with a bimodal peak at 2-6 years and adolescence.
- The most common site is the head and neck (especially the orbit), followed by the genitourinary tract.
- Embryonal subtype is most frequent, has a better prognosis, and includes the sarcoma botryoides (grape-like) variant.
- Alveolar subtype has a worse prognosis, affects extremities, and is linked to t(2;13) translocation.
- Key diagnostic markers include Desmin and Myogenin.
- The characteristic cell is the rhabdomyoblast (tadpole or strap cell).
Unlock the full lesson and continue reading
Signup to continue reading this lesson and unlimited access questions, flashcards, AI notes, and more